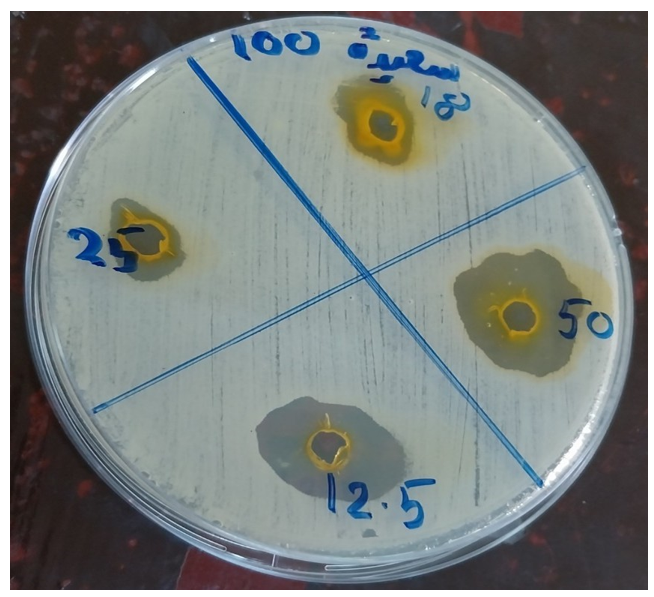

Research Article - (2025) Volume 4, Issue 1
Detection of Antifungal Activity of Turmeric (Curcuma Longa L.) Ethanolic Extract on Candida Species Isolated from Clinical Specimens
Received Date: Feb 18, 2025 / Accepted Date: Mar 17, 2025 / Published Date: Apr 03, 2025
Copyright: ©2025 Ghanem Mohammed Mahjaf, et al. This is an open-access article distributed under the terms of the Creative Commons Attribution License, which permits unrestricted use, distribution, and reproduction in any medium, provided the original author and source are credited.
Citation: Salih, S. S. A., Hammad, K. S., Abdelgader, L. M. A., Mahjaf, G. M. (2025). Detection of Antifungal Activity of Turmeric (Curcuma Longa L.) Ethanolic Extract on Candida Species Isolated from Clinical Specimens. Archives Clin Med Microbiol, 4(1), 01-06.
Abstract
Background: For ages, Curcuma longa has been a mainstay of traditional medicine due to its anti-inflammatory, antioxidant, and antibacterial qualities. The ability of C. longa extracts to prolong shelf life and stop the spoiling of many agricultural products has drawn interest in the search for natural substitutes for artificial preservatives. Candida infections have significantly increased denture wearers, particularly in immunocompromised patients. The surge in resistance to existing antifungal drugs and the increasing number of at-risk patients, along with the limited availability of antifungal medicines that often cause severe side effects, is the root of this problem. These constraints underscore the necessity to develop new and more effective antifungal agents with fewer side effects.
Objectives: This study aimed to evaluate the antifungal activity of turmeric against candida species isolated from clinical specimens of patients suffering from fungal infection.
Materials and Methods: A descriptive study was conducted in the Shendi locality from 2023 to 2024 to determine the activity of ethanolic turmeric extract against Candida species isolated from patients with UTI or Candidiasis. Four Candida species were isolated, and in vitro susceptibility testing was done using well diffusion technique against ethanolic turmeric extract.
Results: Turmeric exhibits antifungal activity against Candida species. The study found that ethanolic turmeric extract affects other candida species more than Candida albicans; the halo diameter in Candida other species is 13 mm, while in Candida albicans, it is 10 mm in concentration is 100%. The halo diameter in candida species was 11.5 mm, 11.5mm, 16.5mm, and 16 mm, respectively. Moreover, the results indicated that turmeric is antimicrobial against candida species, and the effect increased whenever the concentration of turmeric decreased.
Conclusion: Turmeric extract can inhibit Candida species, with a more pronounced impact on Candida of other species than Candida albicans. This study shows how curcumin works against different types of Candida infections. It was discovered that using a mixture of drug formulations or curcumin and its derivatives can be helpful to get past the medication's resistance to fungal diseases, particularly candidiasis.
Keywords
Antimicrobial, Turmeric, UTI, Candida, Herbal Medicine
Introduction
Any plant with a chemical that can be utilized therapeutically or serve as a precursor to the manufacture of valuable pharmaceuticals in one or more of its organs is considered medicinal [1]. The African continent's usage of medicinal herbs precedes the arrival of antibiotics and other contemporary medications. However, the increasing antibiotic resistance is a cause for concern and underscores the urgency of finding alternative solutions. Some antibiotics have unfavorable side effects, such as thrombocytopenic purpura, agranulocytosis, bone marrow suppression, and nausea, which might result in the development of diseases that were previously rare. Both humans and other animals are known to have gastrointestinal illnesses from the diarrhoea genic strains of Staphylococcus aureus and Escherichia coli. Notably, 37% of S. aureus bacteria were recently resistant to ciprofloxacin, whereas 79% of E. coli strains were resistant to ampicillin and 30% to ciprofloxacin [2]. This has prompted researchers to look for novel and different microbial compounds from therapeutic plants [3]. The most critical microorganism found both indoors and outdoors is fungi. While often overlooked, these microorganisms can cause numerous infections, sensory impairment, and toxic and provocative effects, which are just a few of the adverse health effects that fungi have been linked to, according to studies [4]. The genus Candida, a member of the Saccharomyces family and the sarcomaestal class is of particular concern. Numerous species of Candida, including seven species referred to as opportunistic pathogens, coexist in symbiotic relationships with humans and animals. Other species of Candida have uncommon pathogenicity and are frequently saprophytic and symbiotic [5]. In recent decades, many studies have unveiled medicinal herbs' pharmacological potential. Plant-derived antimicrobial agents are promising and practical today, offering a potent and reliable alternative to synthetic drugs. Reviews have highlighted the safety and efficacy of plants and their derivatives as potent antifungal agents, particularly against challenging pathogenic fungal strains like Candida spp., Aspergillus spp., and Dermatophytes [6]. Community-acquired Urinary Tract Infections (UTIs) are a frequent problem worldwide caused by microbial invasion of different urinary tract tissues. Fungi comprise the microbial population that may contribute to fungal uropathogens in UTIs. In the last 2.5 decades, the fungal UTIs due to Candida genus yeast have increased significantly. This rise can be attributed to factors such as increased use of urinary catheters, antibiotic therapy, and the prevalence of diabetes, all of which create favorable conditions for fungal infections [7]. Lower UTI with Candida typically occurs in patients with urinary catheters, often following antibiotic therapy. However, it's important to note that candidal and bacterial infections frequently co-occur, adding a layer of complexity to treatment. C. albicans prostatitis, while infrequent, is a notable complication in patients with diabetes, usually after instrumentation [8]. Renal candidiasis usually spreads hematogenously and commonly originates from the GI tract. Ascending infection is possible and occurs mainly in patients with nephrostomy tubes, other permanent indwelling devices, and stents. At high risk are patients with diabetes and those who are immunocompromised because of tumors, AIDS, chemotherapy, or immunosuppressants. A significant source of candidemia in such high-risk hospitalized patients is an indwelling intravascular catheter. Renal transplantation increases the risk because of the combination of indwelling catheters, stents, antibiotics, anastomotic leaks, obstruction, and immunosuppressive therapy [8]. The spice turmeric has a lot of benefits in traditional medicine, such as the treatment of Jaundice, rheumatoid arthritis, liver disease, eye infections, and dental pain. Also, the remedial effect of turmeric in new medicine has been approved, including anti-inflammatory, hypoglycemic, antioxidant, wound healing, and antimicrobial activities. The mechanism of its antifungal activity is unknown, but it has been suggested that its fungicidal mechanism may involve chitin accumulation on the outer cell wall layer. Curcumin has been proposed as an irresistible antiviral, antibacterial, and antifungal agent, but it is still obscure whether curcumin is as effective as common antifungal drugs, especially against C. albicans [9]. Antimicrobial resistance is a local and significant global health problem threatening human life worldwide. However, we have a potential solution in Turmeric, a substance known for centuries for its antimicrobial effect. In this study, we assess the antifungal activity of different Turmeric concentrations against Candida albicans, contributing to the urgent global effort to combat antimicrobial resistance (Figure 1).
Figure 1: Chemical Structure of Main Compounds Contained in Curcuma Longa L
Materials & Methods
This is a descriptive cross-sectional study conducted in the unique location of Shendi City, aimed at assessing the antifungal effect of turmeric (Curcuma Longa L.). Ethanolic Extract on Candida Species Isolated from Clinical Specimens. From December 2023 to February 2024, Fifty samples (n=50) were collected at different hospitals and clinical centers in Shendi locality, River Nile State, Sudan. Shendi, a town in Northern Sudan, is situated on the east bank of the Nile (150 km) northeast of Khartoum and about (45 km) southwest of the ancient city of Meroe. Shendi, located in the River Nile state, is the center of the Ja'aliin tribe and an important historic trading center. Its principal suburb on the west bank is Al- Matamma. A prominent traditional trade route across the Bayuda desert connects Al-Matamma to Marawi and Napata (250 km) to the Northwest.
Collection and Culture of the Specimens
Specimen depends on disease presentation; the standard submitted sample includes; urine in case of Urinary Tract Infection, vaginal discharge (suspected cases of vaginal thrush) or CSF (when meningitis is suspected), and blood or other exudate from the mucosal surface. Microscopically, Candida yeast cells can be detected as gram-positive cocci in unstained wet preparations or Gram-stained preparations of samples. Culture in Sabouraud dextrose or aerobic blood agar of incubation at 25-37 o C. Interpretation of culture growth was cream-colored colonies appeared after 24-48 hours. The colonies had a distinctive yeast smell, and the budding cells were easily seen by direct microscopy in stained or unstained preparations.
Preparation of Turmeric Ethanolic Extract
Five grams of dry powder of C. longa rhizome (turmeric) was soaked in 25 ml of absolute alcohol (ethanol) overnight to avoid evaporation soaked by a blaster. At this point, a clear solution was visible at the top of the test tube, and debris settled at the bottom. The clear solution at the top was carefully poured into a new test tube so that all debris remained in the original test tubes. This extract of turmeric in ethanol served as a stock for experimentation. This solution was stored at four degrees centigrade to avoid evaporation of the ethanol.
Preparation of Yeast Suspension
Clinical isolates were isolated from different samples and subcultures. Ten ml of normal saline was distributed in test tubes and sterilized in an autoclave at 121 C for 15 minutes. A loopful of purified bacterium was inoculated in sterile normal saline. Inoculum density was compared with the McFarland standard solution.
Testing of Turmeric for Antifungal Activity Against Clinical Isolates
The agar well diffusion method is widely used to evaluate the antimicrobial activity of plants or microbial extracts [10]. It requires careful observation and attention to detail. Using a sterile wire loop, touch 3–5 well-isolated colonies of similar appearance to the test organism and emulsify in 3–4 ml of sterile physiological saline or nutrient broth. In an excellent light, match the suspension's turbidity to the turbidity standard (mix the standard immediately before use). When comparing turbidities, viewing against a printed card or sheet of paper is more accessible. Using a sterile swab, inoculate a plate of Mueller Hinton agar. Remove excess fluid by pressing and rotating the swab against the side of the tube above the level of the suspension. Streak the swab evenly over the surface of the medium in three directions, rotating the plate at approximately 60 to ensure even distribution. With the petri dish lid in place, allow 3–5 minutes for the surface of the agar to dry. Then, a hole 6 to 8 mm in diameter is punched aseptically with a sterile cork borer. Turmeric was diluted into different concentrations: 100%, 50%, 25%, and 12.5% against the selected organisms [10]. Then, agar plates are incubated under suitable conditions. Using a ruler on the underside of the plate, measure the diameter of each zone of inhibition in mm. The endpoint of inhibition was where growth started [11].
Data Analysis
Data were entered, checked, and analyzed using Microsoft Excel 2010 and SPSS (Statistical Package of Social Science) soft program version 28.0. Proportional data was presented as frequencies and percentages.
Results
|
Gender |
Frequency |
Percent % |
|
Male |
22 |
44.0% |
|
Female |
28 |
56.0 % |
|
Total |
50 |
100.0 % |
Table 1: The Distribution of Clinical Specimens According to Gender
|
Type of sample |
Frequency |
Percent % |
|
Urine |
38 |
76.0% |
|
wound swab |
12 |
24.0% |
|
Total |
50 |
100% |
Table 2 : The Distribution of Clinical Specimens According to the Sample Type
|
Variables |
Frequency |
Percent % |
|
Growth |
4 |
8% |
|
No growth |
46 |
92% |
|
Total |
50 |
100.0% |
Table 3 : The Distribution of Clinical Specimens According to Growth
|
Pathogens |
Frequency |
Percent % |
|
Candida albicans |
1 |
25.0 % |
|
Other Candida Spp |
3 |
75.0 % |
|
Total |
4 |
100 |
Table 4 : The Frequency and Percentage of Isolated Organisms
|
Yeast isolated |
Concentration |
|||
|
100% |
50% |
25% |
12.5% |
|
|
Candida albicans |
10 mm |
10 mm |
16 mm |
15 mm |
|
Other Candida |
13 mm |
13 mm |
17 mm |
17 mm |
Table 5 :The Antimicrobial Susceptibility Testing of Turmeric on Yeast is Done According to Species
|
Variable |
Concentration |
|||
|
100% |
50% |
25% |
12.5% |
|
|
Mean of inhibition zone (mm) |
11.5 |
11.5 |
16.5 |
16.0 |
Table 6: The Mean Inhibition Zone of Turmeric Extract Against Isolated Yeast Species
Figure 2: Susceptibility of Other Species of Candida to Turmeric at Different Concentrations
Discussion
One of the hospital's most important fungal infections is candidiasis—Individuals with weakened immune systems. Patients at risk for candidiasis include those who have received organ transplants, those who have cancer or an HIV infection, and those who have received prolonged antibiotic treatment. Furthermore, the patient may die from candidiasis if treatment is not received [12]. Candida albicans is the most prevalent isolate of candidiasis and candidemia, followed by Candida krusei, Candida glabrata, Candida tropicalis, and Candida guilliermondii [13]. However, the various side effects of drugs available for managing candidiasis and the emergence of resistant isolates have made antifungal drug susceptibility testing an essential component of current healthcare management [14]. A typical natural substance in herbal medicine is curcumin. Its antifungal properties are substantial [15]. However, curcumin's weak pharmacodynamic activity in vivo limits its potential benefits. Its low water solubility causes poor oral bioavailability, which causes poor absorption, rapid metabolism, and rapid systemic elimination [16,17]. This study was performed in Shendi town from December 2023 to February 2024. In this study, I attempted to assess the antimicrobial activity of Turmeric in different concentrations against Candida species isolated from clinical specimens. The antifungal activity was tested using the well diffusion assay, and the turmeric samples were tested at 100%, 50%,25%, and 12.5% (v/v) concentrations. The study found that the ethanolic extract of turmeric affected other candida species more than Candida albicans; the halo diameter in candida other species is 13 mm, while in Candida albicans, it is 10 mm in the concentration is 100%. The halo diameter in candida species was 11.5 mm, 11.5mm, 16.5mm, and 16 mm, respectively. Our research has shown that turmeric is antimicrobial against candida species, with the antimicrobial effect increasing as the concentration of turmeric decreases. This finding is in line with those of Gurning Kasta, who also demonstrated the antimicrobial properties of turmeric. In our research, we conducted antibacterial testing with various concentrations, including 500 mg/mL, 400 mg/mL, 300 mg/mL, 200 mg/mL, 100 mg/mL, 50 mg/mL, and 25 mg/mL. We used DMSO 10% as a negative control, amoksisilin as a positive control for bacteria, and Ketoconazole as a positive control for fungi. The results of our testing showed that the ethanol extract of rhizome turmeric exhibited decreasing diameters of inhibition against albicans at these concentrations, with diameters of 15.2mm, 12.52mm, 12.0mm, 10.57mm, 9.88mm, 9.38mm, and 8.98mm, respectively [18]. Also, Jeevitha and his colleagues showed that There was complete inhibition of the growth of all four dilutions of Candida at a concentration of 800 µl, which is considered as the MIC of alcoholic extract of turmeric on C. albicans, and the minimum fungicidal concentration was at 1600 µl [19]. Our study disagrees with Tahereh and his colleagues in their results; this study suggested that curcumin extract did not affect the inhibition of Candida albicans in a laboratory environment [20]. Babaii and his colleagues show that an inhibition halo was observed for curcumin extract, and the halo diameter was 6mm for 5% curcumin [9]. Numerous novel curcumin and turmeric compounds have been discovered to effectively reduce and inhibit the Candida agents, according to the research presented in this publication. Nevertheless, the precision of the results was impacted by specific research limitations. These restrictions included using different turmeric or curcumin extract dosages and using various techniques for extract manufacturing. Additionally, several investigations were carried out in vitro; no in vivo studies were carried out to demonstrate the impact of the curcumin and Curcuma longa extract.
Conclusion
The effects of turmeric and its components on various Candida species were investigated in this study. The literature reviews covered different medications based on curcumin in this study. Compared to its traditional use and the spices used in food, curcumin's influence on fungal candidiasis infection has increased dramatically with changes in its prescription and pharmaceutical form. The pharmaceutical formulations can also be used with other antifungal medications to increase curcumin's efficacy. By using fewer chemical medications, these formulations can lessen side effects, and when drug resistance is addressed, their combined impact is enhanced. Herbal medicine-based therapeutic approaches, with their long-standing use and proven effectiveness, offer a reliable and reassuring option for treatment. Turmeric is a common herbal remedy for fungal infections, particularly candidiasis, and it also works quite well as a medication, instilling optimism about its potential efficacy.
Consent
The patient’s written consent has been collected.
Ethical Approval
The study was approved by the Department of Medical Microbiology in Medical Laboratory Sciences at Shendi University; the study was matched to the ethical review committee board. Sample collection was done after signing a written agreement with the participants. Permission for this study was obtained from the local authorities in the area. This study's aims and benefits were explained with the assurance of confidentiality. All protocols in this study were done according to the Declaration of Helsinki (1964).
Acknowledgement
Firstly, praise Allah for giving us the strength to complete this study. Thanks to all staff of Medical Laboratories Sciences, Department of Medical Microbiology at Shendi University, Shendi-Sudan, for helping complete this study.
Sources of Funding
There was no specific grant for this research from any funding organization in the public, private, or nonprofit sectors.
Conflict of interest
The authors have declared that no competing interests exist.
References
- Sofowora, L. A. (1982). Medicinal plants and traditional medicine in Africa. Spectrum Book Ltd, Ibadan. 32.
- Mello, L. V. (2008). Antimicrobial properties and action of galangal on Staphylococcus aureus. Journal of Food Science and Technology. 39:124-125.
- Aliero, A. A., & Afolayan, A. J. (2006). Antimicrobial activity of Solanum tomentosum. African Journal of Biotechnology, 5(4), 369-372.
- Bush, R. K., Portnoy, J. M., Saxon, A., Terr, A. I., & Wood, R.A. (2006). The medical effects of mold exposure. Journal of Allergy and Clinical Immunology, 117(2), 326-333.
- Karahan, Z. C., Güriz, H., AÄ?ırbaÅ?lı, H., Balaban, N., Göçmen,J. S., Aysev, D., & Akar, N. (2004). Genotype distribution of Candida albicans isolates by 25S intron analysis with regard to invasiveness. Mycoses, 47(11â?12), 465-469.
- Cheraghipour, K., Ezatpour, B., Masoori, L., Marzban, A., Sepahvand, A., Rouzbahani, A. K., ... & Mahmoudvand,H. (2021). Anti-Candida activity of curcumin: A systematicreview. Current drug discovery technologies, 18(3), 379-390.
- Andrade, S. S., Sader, H. S., Jones, R. N., Pereira, A. S., Pignatari, A. C., & Gales, A. C. (2006). Increased resistance to first-line agents among bacterial pathogens isolated from urinary tract infections in Latin America: time for local guidelines?. Memórias do Instituto Oswaldo Cruz, 101, 741- 748.
- Howes DS, Henry SM. Urinary Tract Infection, Female. 2005. Emedicine: http://www. emedicine. com/EMERG/topic626. htm.
- Neda, B., & Shiva, Z. (2016). Inhibitory Effect of Curcumin on Candida-albicans compared with Nystatin: an in-vitro Study. Journal of Dental Materials & Techniques, 5(4).
- Ibrahim, T. A., & OYINLOYE, B. O. J. (2011). 1. ANTIBACTERIAL ACTIVITY OF HERBAL EXTRACTS AGAINST MULTI DRUG RESISTANT STRAINS OF BACTERIA FROM CLINICAL ORIGIN BY 1 TA IBRAHIM, 2 BO OPAWALE AND 3 JMA OYINLOYE. Life sciencesleaflets, 15, 490-to.
- Cheesbrough, M. (2006). District laboratory practice in tropical countries, part 2. Cambridge university press.
- Beck-Sagué, C., Jarvis, W. R. (1993). System NNIS. National NosocomialInfections Surveillance System. Secular trends in the epidemiologyof nosocomial fungal infections in the United States, 1980-1990. JInfect Dis, 167(5), 1247-51.
- Ang, B. S. P., Telenti, A., King, B., Steckelberg, J. M., & Wilson, W. R. (1993). Candidemia from a urinary tract source: microbiological aspects and clinical significance. Clinical Infectious Diseases, 17(4), 662-666.
- Neelofar, K., Shreaz, S., Rimple, B., Muralidhar, S., Nikhat, M., & Khan, L. A. (2011). Curcumin as a promising anticandidal of clinical interest. Canadian Journal of Microbiology, 57(3), 204-210.
- Zorofchian Moghadamtousi, S., Abdul Kadir, H., Hassandarvish, P., Tajik, H., Abubakar, S., & Zandi, K. (2014). A review on antibacterial, antiviral, and antifungal activity of curcumin. BioMed research international, 2014(1), 186864.
- Anand, P., Kunnumakkara, A. B., Newman, R. A., & Aggarwal,B. B. (2007). Bioavailability of curcumin: problems andpromises. Molecular pharmaceutics, 4(6), 807-818.
- Ireson, C., Orr, S., Jones, D. J., Verschoyle, R., Lim, C. K., Luo, J. L., ... & Gescher, A. (2001). Characterization of metabolites of the chemopreventive agent curcumin in human and rat hepatocytes and in the rat in vivo, and evaluation of their ability to inhibit phorbol ester-induced prostaglandin E2 production. Cancer research, 61(3), 1058-1064.
- Kasta, G. (2020). Antimicrobial activity of ethanol extract of rhizome turmeric (Curcuma longa L.) for growth of Escherichia coli, Staphylococcus aureus and Candida albicans. Asian Journal of Pharmaceutical Research and Development, 8(3), 5-8.
- Murugesh, J., Annigeri, R. G., Mangala, G. K., Mythily, P. H., & Chandrakala, J. (2019). Evaluation of the antifungal efficacy of different concentrations of Curcuma longa on Candida albicans: An: in vitro: study. Journal of Oral and Maxillofacial Pathology, 23(2), 305.
- Nosratzehi, T., Nosratzehi, M., Nosratzehi, S., & Lotfi,F. (2019). The comparison of the effect of curcumin with nystatin on inhibition level of Candida albicans. Journal of experimental pharmacology, 93-97.

